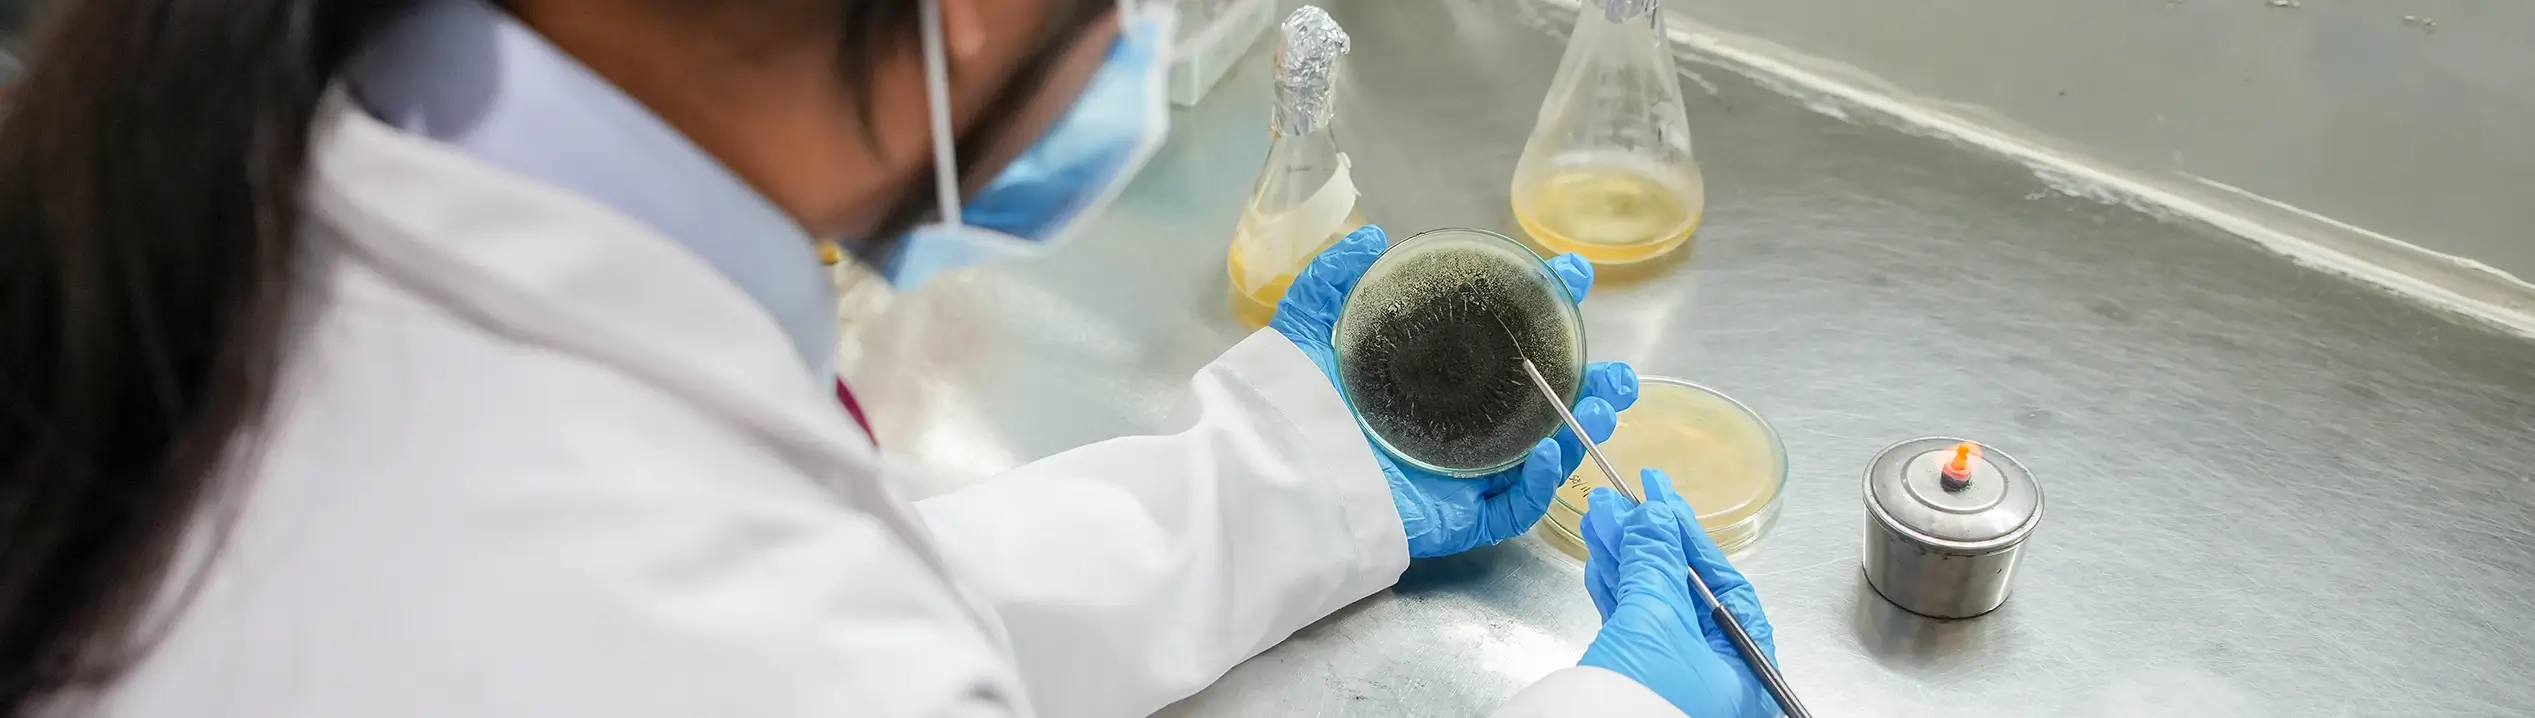
B.Sc Forensic Science

Through a carefully structured curriculum, students gain a strong theoretical foundation as well as extensive practical training in laboratory techniques. The programme covers essential subjects, including forensic toxicology, forensic biology, forensic chemistry, forensic anthropology, forensic psychology, criminalistics, digital forensics, and the legal aspects of forensic science, equipping students with the knowledge and skills to collect, preserve, analyse, and interpret physical and digital evidence.
Designed to foster analytical thinking, technical expertise and ethical understanding, the curriculum balances classroom instruction with hands-on experience in laboratories, simulated crime scene exercises and fieldwork. Students also learn about the legal framework governing evidence handling, courtroom procedures and the role of forensic science within the criminal justice system, ensuring a holistic view of the profession. By emphasising both scientific rigour and investigative application, the programme prepares graduates for careers in forensic laboratories, law enforcement agencies, cybercrime investigation units, private investigative firms and research institutions.